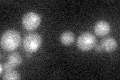
YDR480W
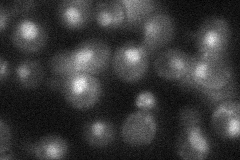
YDR480W
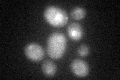
YDR480W
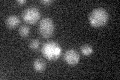
YDR480W

View description
Regulatory protein of unknown function, pheromone-inducible, involved in the regulation of mating-specific genes and the invasive growth pathway, required for MAP-kinase imposed repression, inhibits pheromone-responsive transcription
Localization:
Intensity:
Fold change:
Significance:
-
C’ GFP library in SD
nucleus19.57 -
N' NOP1pr-GFP in SD

nucleus133.441 -
N' TEF2pr-mCherry in SD

nucleus93.1446 -
N' NATIVEpr-GFP in SD
nucleus30.0328 -
N' TEF2pr-VC and Cyto-VN in SD

punctate,nucleus33.5296 -
C’ GFP library in SD+DTT
nucleus18.260.93No -
C’ GFP library in SD+H2O2

nucleus18.370.93No -
C’ GFP library in Starvation Media
nucleus17.960.91No -
C’ GFP library on the background of Pup2-DaMP

nucleus -
C’ GFP library on the background of CCT mutant

nucleus20.03751.02315No
